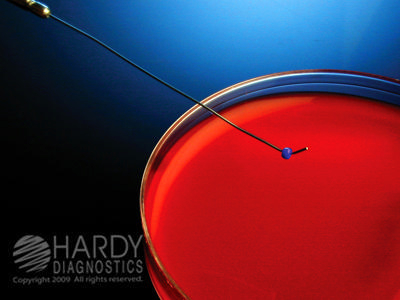

Needle Nichrome ,Each
$ 44.93
|
|
Details:
Needle nichrome, with aluminum handle^ Handle has insulated sleeve, 5 per package, by SCI. Used to streak various liquids, suspensions, bacteria, and other specimen on to culture media and/or petri dishes for purposes of study and growth.
Additional Information
| SKU | 23437995 |
|---|---|
| UOM | EACH |
| UNSPSC | 41106200 |
| Manufacturer Part Number | 3060 |
| Product Dimensions | 1X1X3 Inches |
| Product Weight | 1 |
